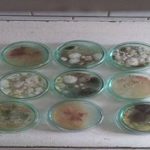

Лабораторний аналіз лісопатологічних проб, який проводять фахівці ДСЛП «Харківлісозахист», є важливою складовою у системі моніторингу та захисту лісів від хвороб і шкідників. Основна мета таких досліджень — встановлення точного діагнозу щодо причини ураження лісових насаджень, визначення виду патогенів або шкідників, а також оцінка загрози, яку вони становлять для лісу. Це дозволяє оперативно приймати рішення про необхідні заходи з оздоровлення лісу або запобігання поширенню уражень.
Аналіз починається з виїзду спеціалістів на місце ураження, де вони проводять ретельне обстеження лісових ділянок і відбирають зразки — фрагменти хвої, кори, деревини, листя, коріння, ґрунту, а також живих або мертвих комах. Ці проби доставляються до лабораторії у спеціальних умовах, що гарантують збереження їх властивостей.
У лабораторії проводяться мікроскопічні, мікологічні, ентомологічні та фітопатологічні дослідження. Фахівці вивчають морфологічні ознаки збудників, культивують патогенні організми на живильних середовищах, ідентифікують види шкідників, визначають ступінь ураження та потенційні шляхи його поширення. Наприклад, серед типових збудників хвороб можуть виявити кореневу губку (Heterobasidion annosum), яка вражає корені та нижню частину стовбура, або некротичні гриби роду Armillaria.
Серед шкідників часто трапляються верхівковий короїд (Ips acuminatus), шестизубчастий короїд (Ips sexdentatus), а також інші види стовбурових шкідників, які швидко поширюються і здатні призводити до загибелі великих площ лісу. Отримані результати дають змогу не лише точно встановити природу ураження, але й підібрати ефективні заходи реагування.
На основі лабораторного висновку спеціалісти готують рекомендації щодо проведення відповідних лісогосподарських заходів — від хімічного або біологічного захисту до санітарних рубок і подальшого моніторингу. Таким чином, лабораторний аналіз лісопатологічних проб є одним з ключових інструментів у забезпеченні здоров’я лісів та збереженні екосистем.